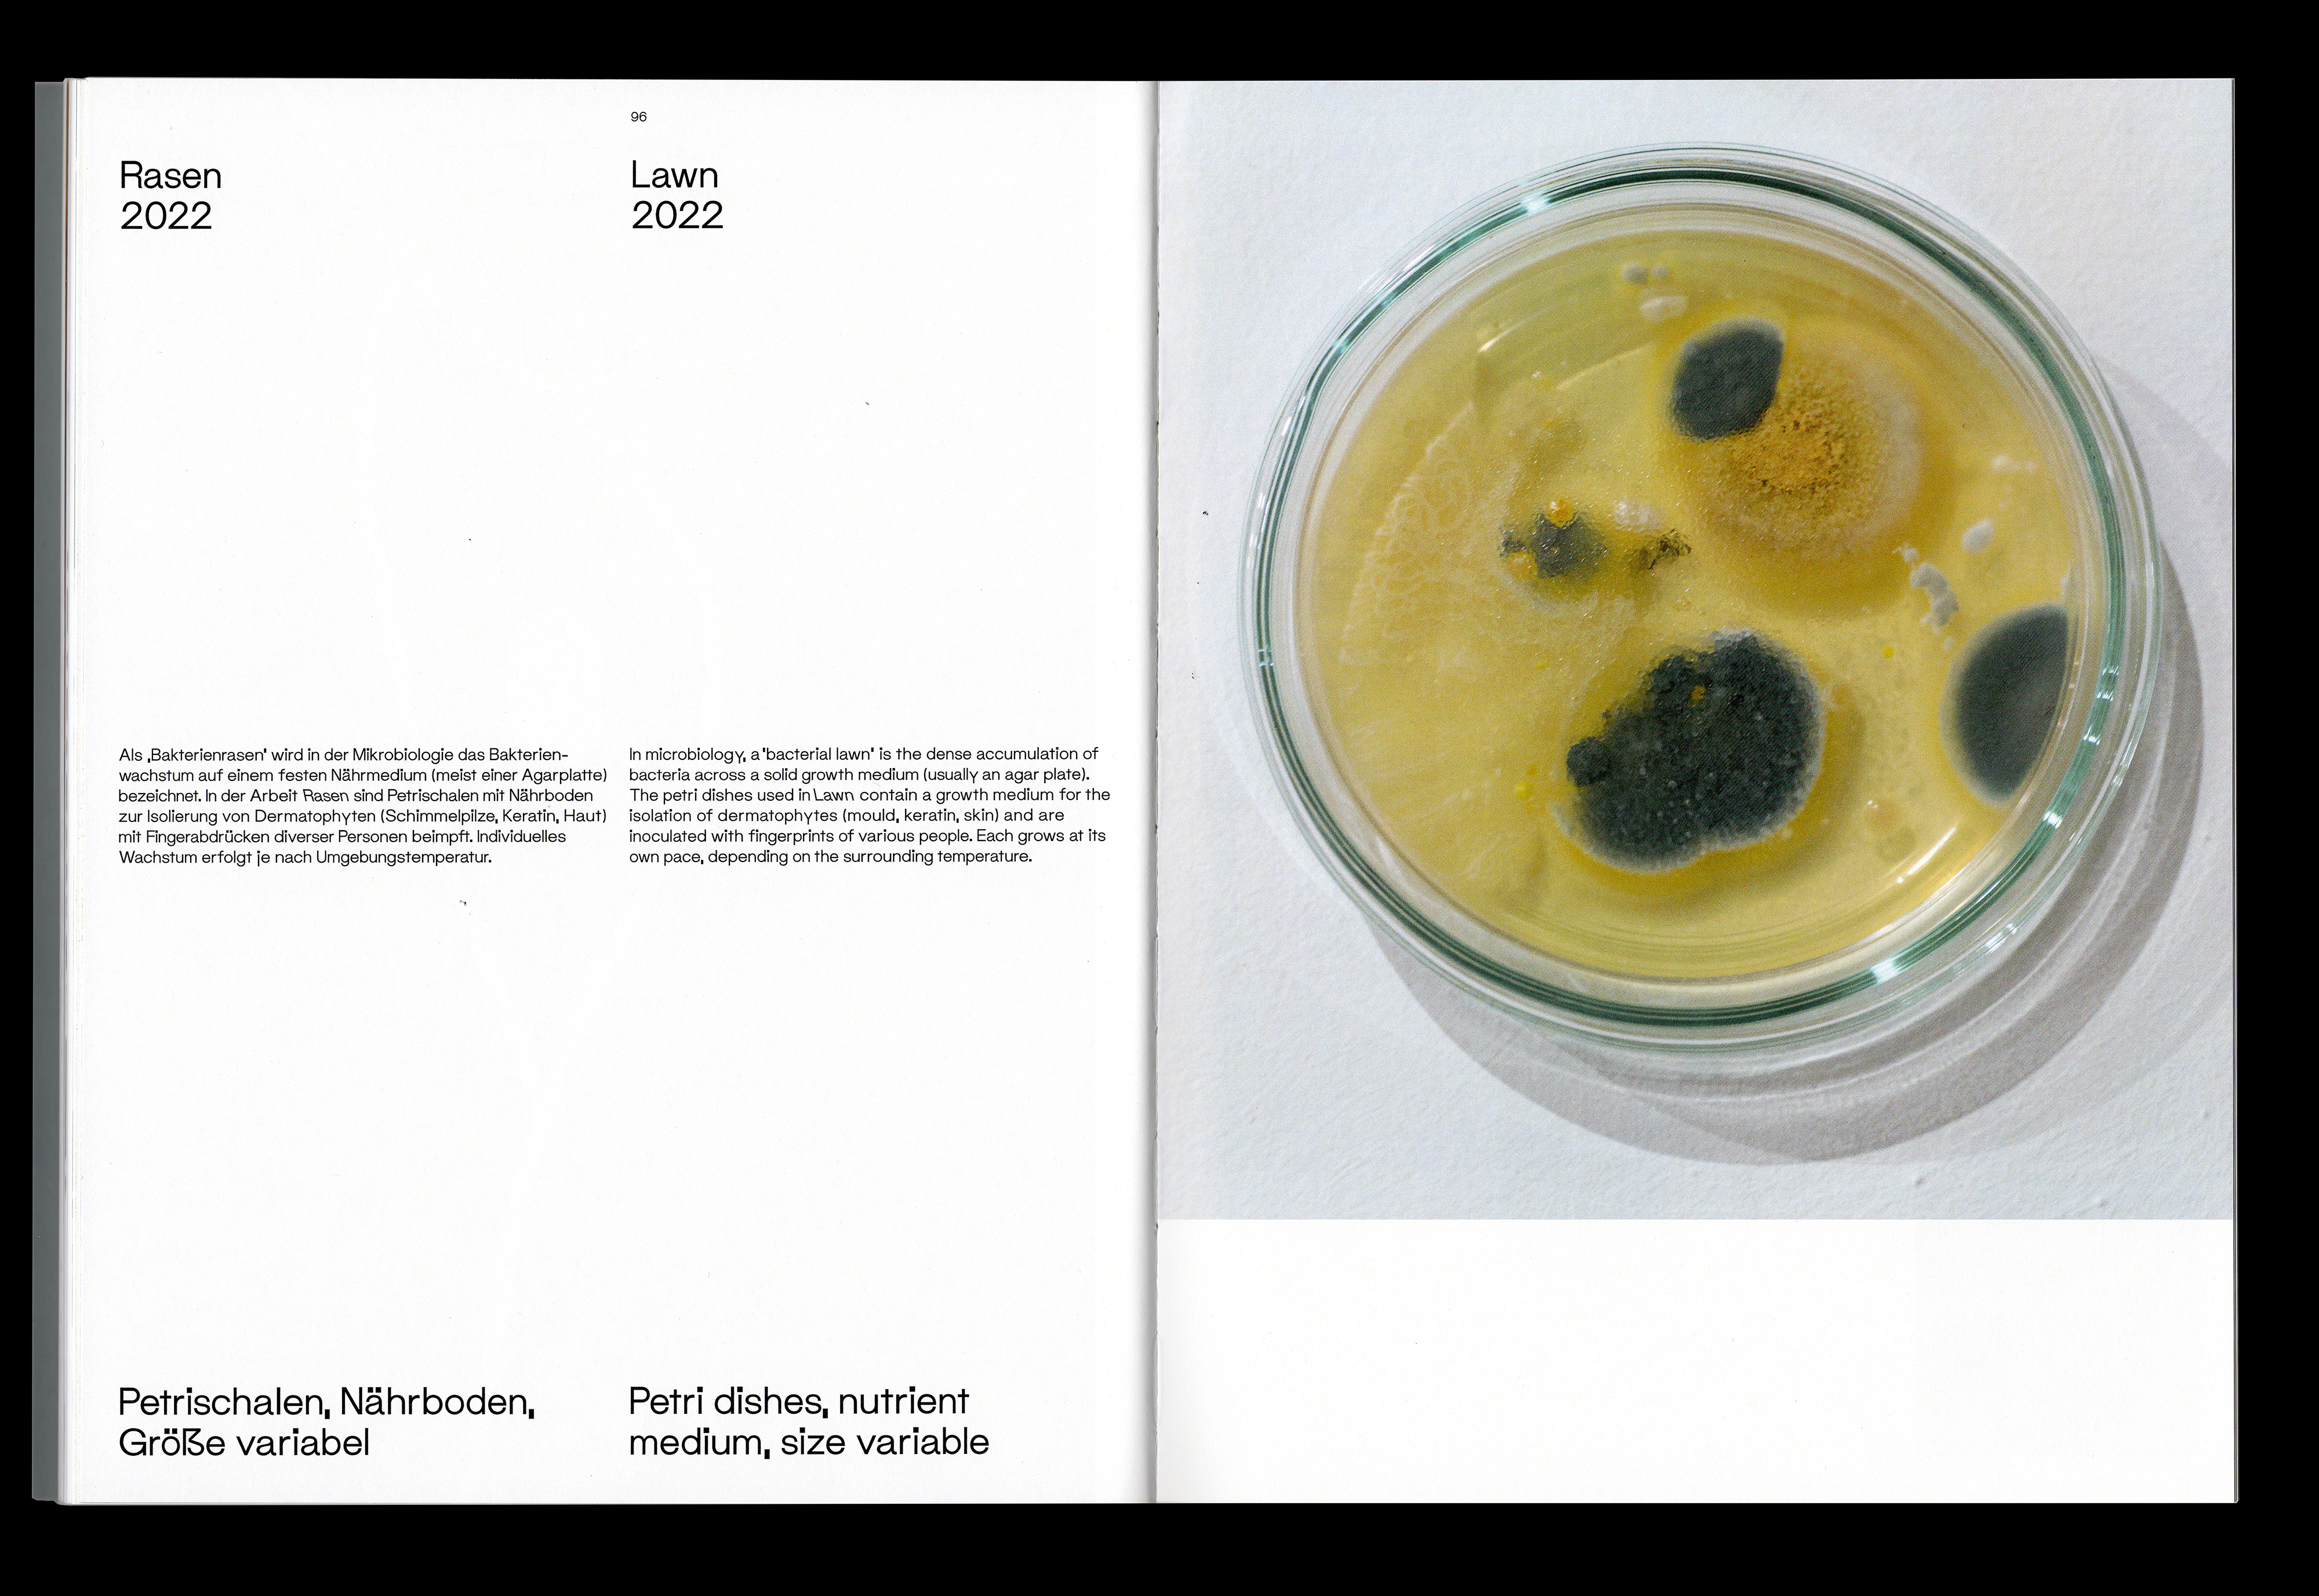

Katalog für die Künstlerin Beate Gärtner. Design als Schweizer Broschur mit offener Fadenheftung. Zweisprachiges Layout durch direkte gegenüber Stellung der beiden Sprachen im Dialog.
Catalogue for the artist Beate Gärtner. Designed as a Swiss brochure with open thread stitching. Bilingual layout through direct juxtaposition of the two languages in dialogue.